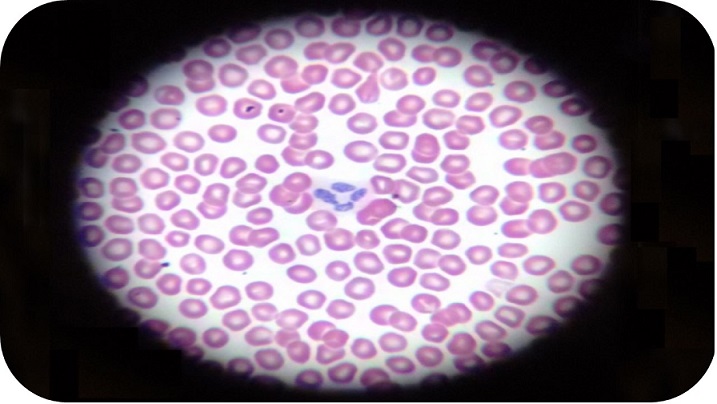
Microscopio simple. Mucho más que una simple lupa

Vol. 16 Núm. 2 (2019): 16(2). Abril de 2019
Fundamentos y líneas de trabajo
-

¿Cómo llega el agua a las nubes? Construcción de explicaciones sobre cambios de estado en educación infantil
Experiencias, recursos y otros trabajos
-

Una experiencia sobre seguridad alimentaria para trabajar la argumentación en el aula de educación secundaria

Aprendizaje basado en un proyecto de gamificación: vinculando la educación universitaria con la divulgación de la geomorfología de Chile

Qué proyectos STEM diseña y qué dificultades expresa el profesorado de secundaria sobre Aprendizaje Basado en Proyectos
La educación científica hoy
-
Ciencia recreativa
-
Educación científica y sostenibilidad
-
Formación del profesorado de ciencias
-
-